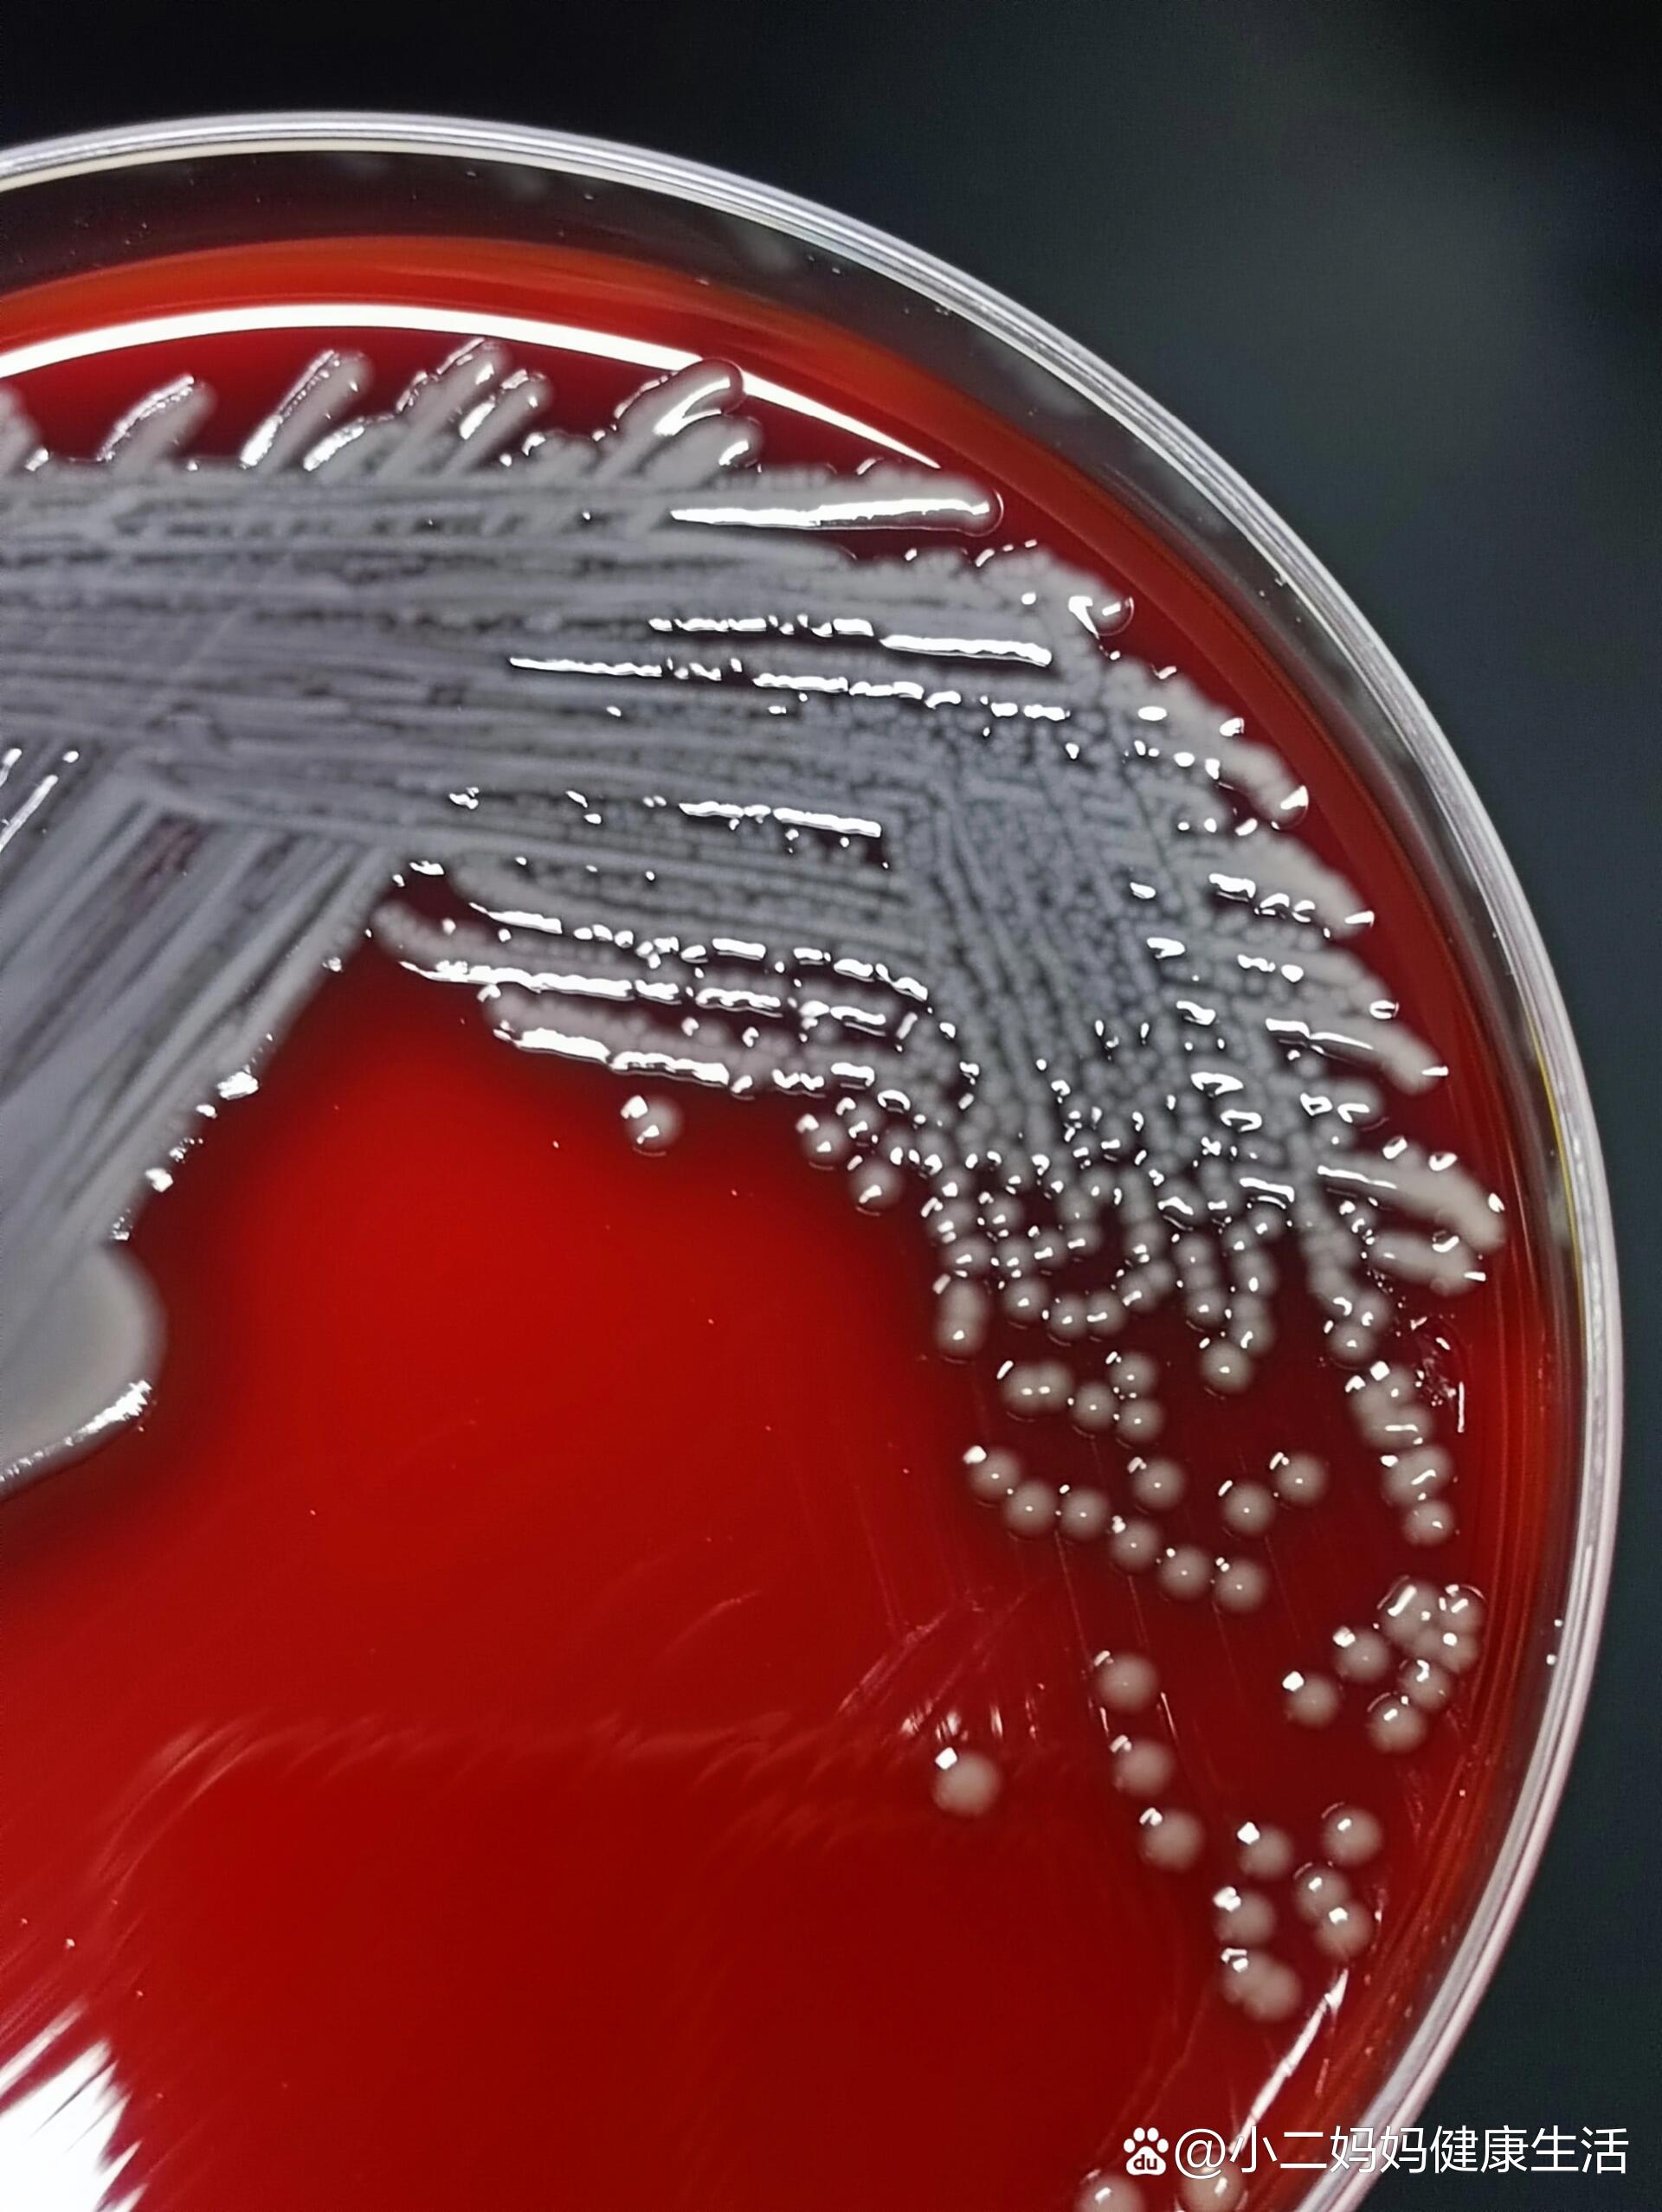
颗颗分明的杀鲑气单胞菌
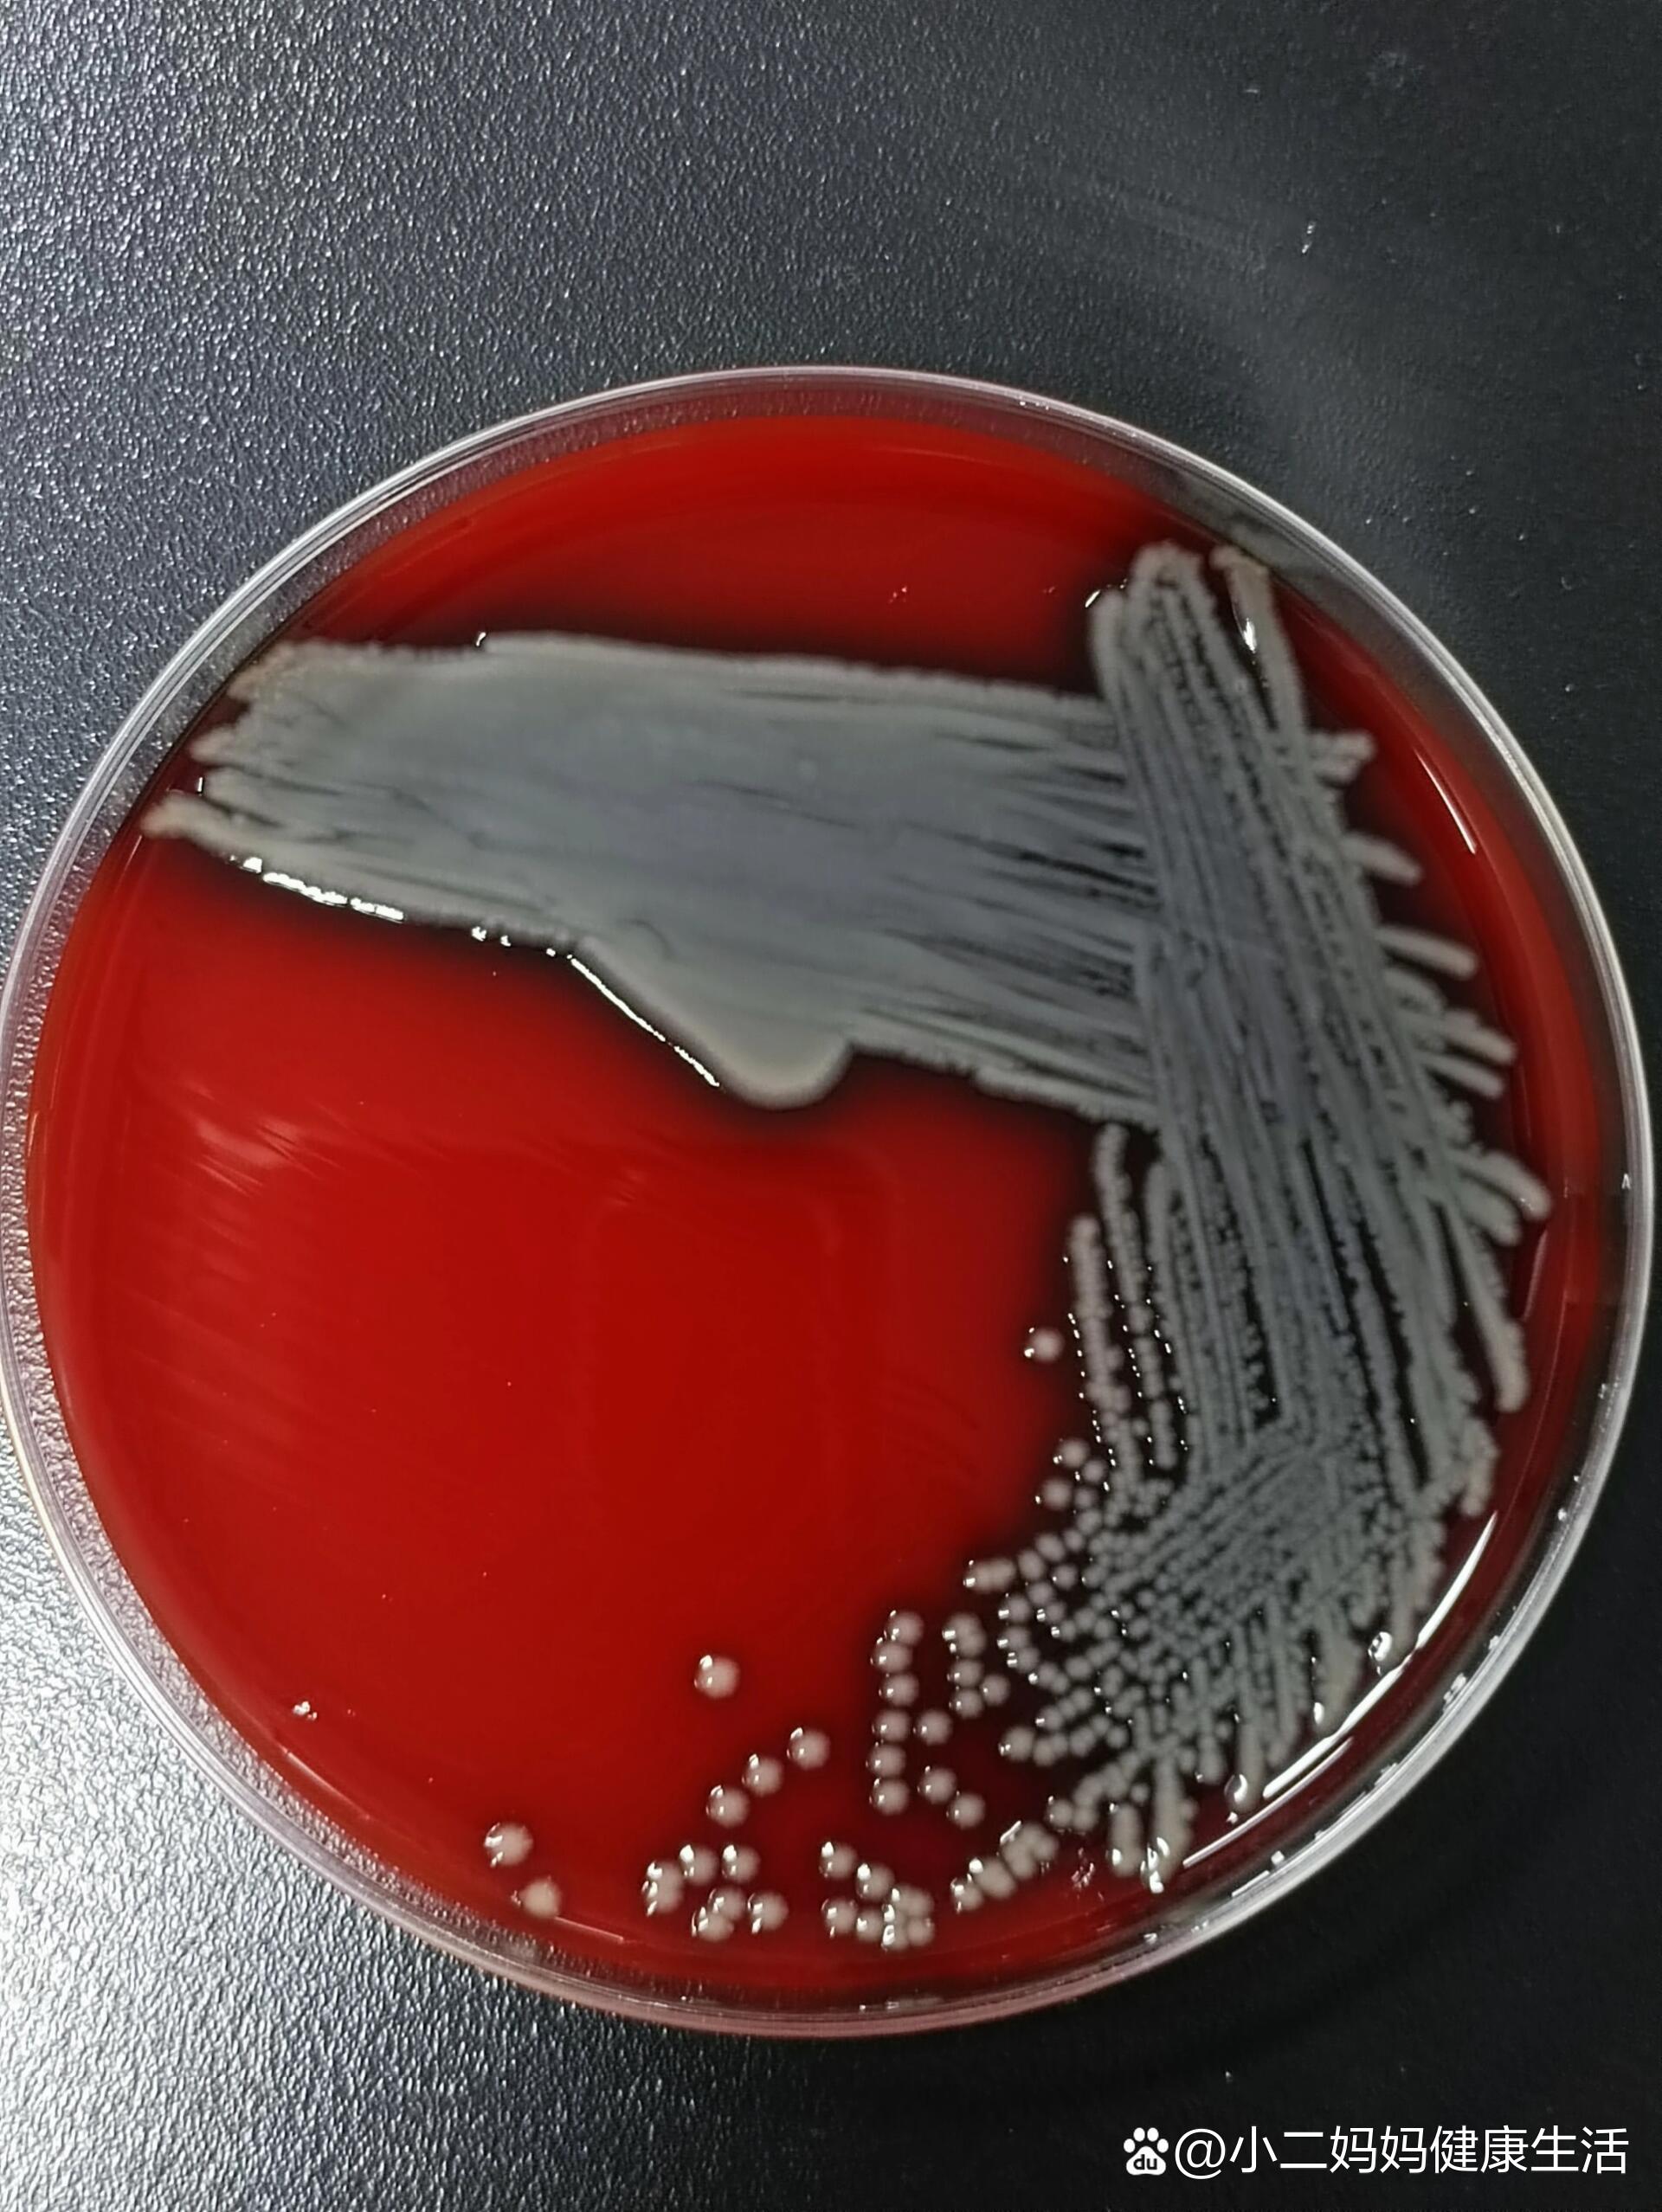
颗颗分明的杀鲑气单胞菌

杀鲑气单胞菌

颗颗分明的杀鲑气单胞菌
图片尺寸1920x2556
颗颗分明的杀鲑气单胞菌
图片尺寸1920x2556
杀鲑气单胞菌shbcc d17882非模式菌株营养肉汁琼脂培养基27℃培养
图片尺寸800x800
鱼类检疫方法 第6部分:杀鲑气单胞菌(标准状态:现行)
图片尺寸959x1356
包邮 冻干粉 杀鲑气单胞菌日本鲑亚种 lmg 3782 0代菌种
图片尺寸800x800
【技术分享】低温期注意杀鲑气单胞菌引起的溃烂病
图片尺寸1080x745
杀鲑气单胞菌日本鲑亚种
图片尺寸600x600
【技术分享】低温期注意杀鲑气单胞菌引起的溃烂病
图片尺寸1060x1026
【案例分享】低温期鳜鱼游水死亡,检出杀鲑气单胞菌
图片尺寸533x547
杀鲑气单胞菌噬菌体,包含其的杀菌组合物及其应用的制作方法
图片尺寸633x1000
南京农业大学王虎虎教授团队:杀鲑气单胞菌分泌的效应蛋白 hap 与肉类
图片尺寸3549x1297
一种利用纳米锌制备的杀鲑气单胞菌灭活疫苗
图片尺寸1000x574
超声和绿原酸联用对杀鲑气单胞菌生物膜的协同杀菌作用_参考网
图片尺寸1756x673
不同来源杀鲑气单胞菌毒力因子的比较基因组学研究_参考网
图片尺寸3777x3093
南京农业大学王虎虎教授团队:杀鲑气单胞菌分泌的效应蛋白 hap 与肉类
图片尺寸2368x1721
气单胞菌属
图片尺寸900x601
7粪肠球菌
图片尺寸960x1280
7粪肠球菌
图片尺寸960x1280
不同来源杀鲑气单胞菌毒力因子的比较基因组学研究_参考网
图片尺寸1984x1787
6-2008 鱼类检疫方法 第6部分:杀鲑气单胞菌
图片尺寸800x800